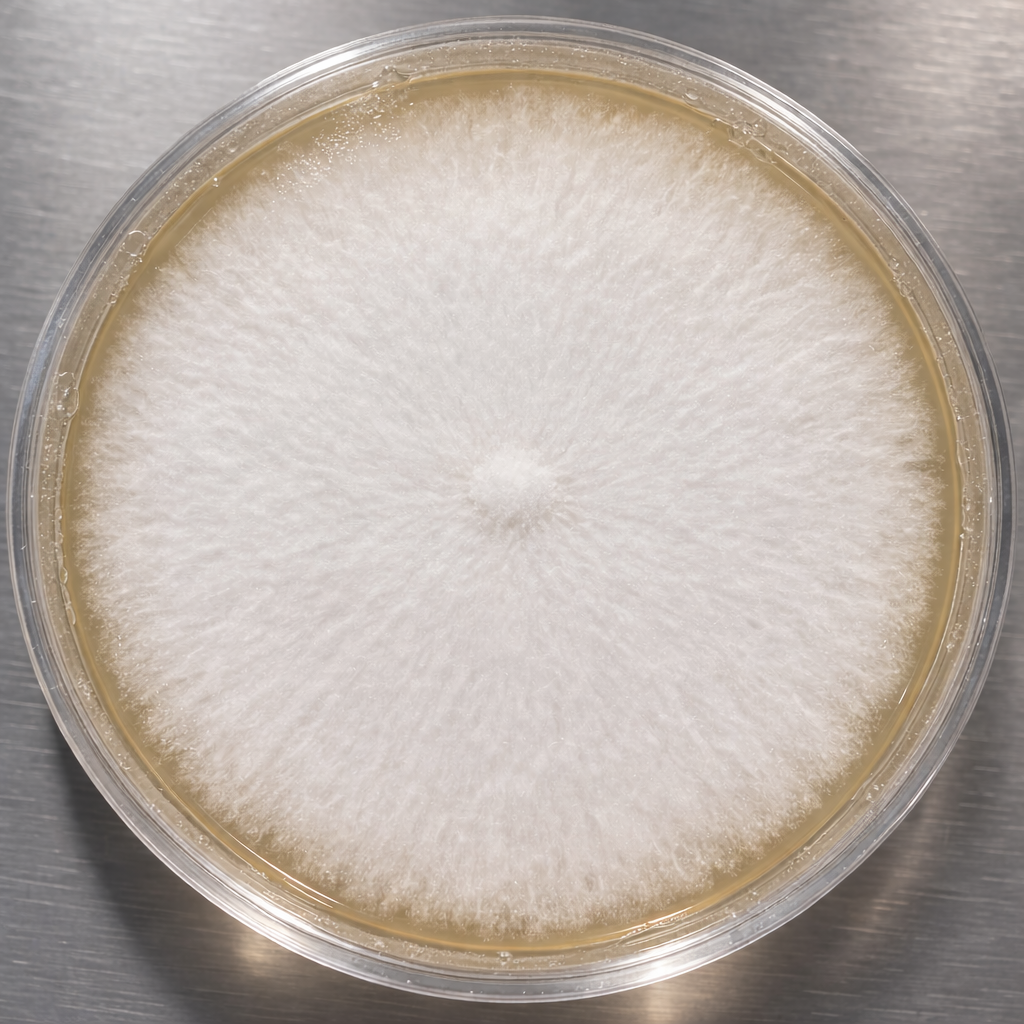

Description
Aniseed Toadstool Mushroom Culture
Aniseed Toadstool (Clitocybe odora) Mushroom Culture.
Each culture plate is a 100x15mm petri dish inoculated with fresh Aniseed Toadstool (Clitocybe odora) mycelium growing on malt extract agar (MEA), and will arrive actively colonizing.
Aniseed Toadstool Mushroom Culture Lab Notes
At Out-Grow's mycology lab, we have observed the following traits of this mushroom culture:
Aniseed Toadstool (Clitocybe odora) mycelium appears white to off-white on culture media, with a cottony to slightly fluffy texture and moderate density typical of saprotrophic agarics. Growth is radial and circular, typically colonizing a 100mm plate in approximately 1-2 weeks at an optimal temperature of 59–72°F. Note: the distinctive anise aroma of this species may be noticeable even at the culture stage — a natural indicator of a healthy, vigorous culture.
Mushroom Culture Use
Mushroom cultures, typically on MEA culture plates, are used to grow and preserve mycelium. In most cases, sterile transfers of agar wedges from this plate are used to inoculate fresh culture media or sterilized grain spawn.
Mushroom Culture Storage
Your mushroom culture can be wrapped in parafilm and stored at normal room temps, in a sealed baggie, for up to 6 months. Out-Grow recommends you replate your mushroom culture every 6 months to ensure longevity of your purchase.
Store fully colonized plates at 35–41°F in darkness, sealed to prevent desiccation. Plan to refresh cultures every 3-6 months to maintain viability.
Mushroom Cultures Are Made to Order
All mushroom culture plates are made to order. Once your order is received, Out-Grow will inoculate your plate within 1-3 days. Your mushroom culture will then be incubated in our mycology lab for approximately 7-14 days, or until clean healthy mycelium has been verified by our mycologist. Once verified, your order will be shipped promptly. Please allow an additional week for your mushroom culture to fully colonize upon arrival, as colonization time varies by species.
Description
Aniseed Toadstool Mushroom Culture
Aniseed Toadstool (Clitocybe odora) Mushroom Culture.
Each culture plate is a 100x15mm petri dish inoculated with fresh Aniseed Toadstool (Clitocybe odora) mycelium growing on malt extract agar (MEA), and will arrive actively colonizing.
Aniseed Toadstool Mushroom Culture Lab Notes
At Out-Grow's mycology lab, we have observed the following traits of this mushroom culture:
Aniseed Toadstool (Clitocybe odora) mycelium appears white to off-white on culture media, with a cottony to slightly fluffy texture and moderate density typical of saprotrophic agarics. Growth is radial and circular, typically colonizing a 100mm plate in approximately 1-2 weeks at an optimal temperature of 59–72°F. Note: the distinctive anise aroma of this species may be noticeable even at the culture stage — a natural indicator of a healthy, vigorous culture.
Mushroom Culture Use
Mushroom cultures, typically on MEA culture plates, are used to grow and preserve mycelium. In most cases, sterile transfers of agar wedges from this plate are used to inoculate fresh culture media or sterilized grain spawn.
Mushroom Culture Storage
Your mushroom culture can be wrapped in parafilm and stored at normal room temps, in a sealed baggie, for up to 6 months. Out-Grow recommends you replate your mushroom culture every 6 months to ensure longevity of your purchase.
Store fully colonized plates at 35–41°F in darkness, sealed to prevent desiccation. Plan to refresh cultures every 3-6 months to maintain viability.
Mushroom Cultures Are Made to Order
All mushroom culture plates are made to order. Once your order is received, Out-Grow will inoculate your plate within 1-3 days. Your mushroom culture will then be incubated in our mycology lab for approximately 7-14 days, or until clean healthy mycelium has been verified by our mycologist. Once verified, your order will be shipped promptly. Please allow an additional week for your mushroom culture to fully colonize upon arrival, as colonization time varies by species.